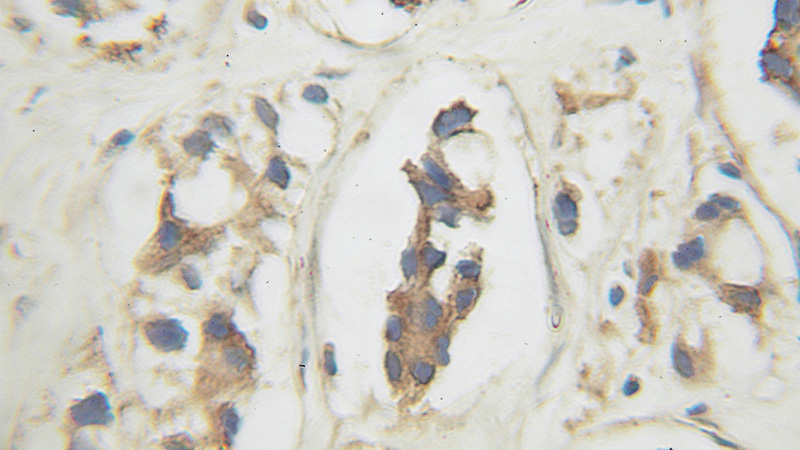
Immunohistochemical of paraffin-embedded human prostate cancer using Catalog No:109546(CREB3 antibody) at dilution of 1:100 (under 25x lens)

-
Product Name
CREB3 antibody
- Documents
-
Description
CREB3 Rabbit Polyclonal antibody. Positive IHC detected in human prostate cancer tissue. Positive IP detected in PC-3 cells. Positive WB detected in PC-3 cells, Jurkat cells. Observed molecular weight by Western-blot: 40-64kd
-
Tested applications
ELISA, WB, IHC, IP
-
Species reactivity
Human; other species not tested.
-
Alternative names
CREB 3 antibody; CREB3 antibody; LUMAN antibody; LZIP antibody
-
Isotype
Rabbit IgG
-
Preparation
This antibody was obtained by immunization of CREB3 recombinant protein (Accession Number: NM_006368). Purification method: Antigen affinity purified.
-
Clonality
Polyclonal
-
Formulation
PBS with 0.02% sodium azide and 50% glycerol pH 7.3.
-
Storage instructions
Store at -20℃. DO NOT ALIQUOT
-
Applications
Recommended Dilution:
WB: 1:200-1:2000
IP: 1:200-1:2000
IHC: 1:20-1:200
-
Validations

PC-3 cells were subjected to SDS PAGE followed by western blot with Catalog No:109546(CREB3 antibody) at dilution of 1:300
Immunohistochemical of paraffin-embedded human prostate cancer using Catalog No:109546(CREB3 antibody) at dilution of 1:100 (under 25x lens)

IP Result of anti-CREB3 (IP:Catalog No:109546, 4ug; Detection:Catalog No:109546 1:500) with PC-3 cells lysate 1800ug.
-
Background
CREB3, also named as LZIP and Luman, belongs to the bZIP family and ATF subfamily. It is a transcription factors activated upon intramembrane proteolysis (RIP), binds the cAMP response element (CRE) (consensus: 5'-GTGACGT[AG][AG]-3'), a sequence present in many viral and cellular promoters. CREB3 binds to and requires HCFC1 as a coactivator. The activity and expression are suppressed when the HCFC1-CREB3 complex binds with CREBZF. Participates in LKN-1/CCL15-induced chemotaxis signaling. CREB3 is N-glycosylated and released by proteolysis. So the MW of CREB3 emirate 40kd to 64kd.
-
References
- DenBoer LM, Iyer A, McCluggage AR, Li Y, Martyn AC, Lu R. JAB1/CSN5 inhibits the activity of Luman/CREB3 by promoting its degradation. Biochimica et biophysica acta. 1829(9):921-9. 2013.
Related Products / Services
Please note: All products are "FOR RESEARCH USE ONLY AND ARE NOT INTENDED FOR DIAGNOSTIC OR THERAPEUTIC USE"
